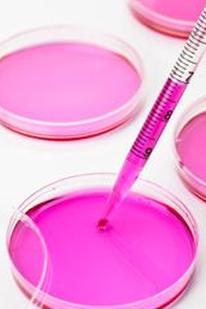

В связи с недавними изменениями в правилах, регулирующих исследования стволовых клеток, большая часть американской общественности задается вопросом: «Как человеческий эмбрион связан со стволовыми клетками?» Некоторые имеют лишь смутное представление о том, что такое стволовые клетки на самом деле, и многие не знают, почему ученые так заинтересованы в их изучении. Лечение стволовыми клетками и методы лечения различных заболеваний могут спасти жизни. Вопреки тому, что могут подумать американцы, эти открытия не обязательно должны стоить потенциальных человеческих жизней.
Что такое стволовая клетка?
Чтобы ответить на вопрос, как человеческий эмбрион связан со стволовыми клетками, необходимо понять, что такое стволовая клетка. Проще говоря, стволовая клетка — это тип неспецифической незрелой клетки, которая может развиться в специализированную взрослую клетку в организме человека. Тело может зайти так далеко в своем излечении; как только ткань разрушается или ее ДНК повреждается, эта часть тела больше не может функционировать. Например, сердечные приступы убивают клетки сердца, и это повреждение необратимо. Однако, если бы сердце можно было заставить производить новые сердечные клетки для замены мертвых клеток, у человека мог бы быть шанс на более долгую и полноценную жизнь.
Стволовые клетки также потенциально могут быть использованы для регенерации полностью функционирующих нервных клеток у жертв травм позвоночника или клеток головного мозга у людей с повреждением головного мозга. Используя стволовые клетки, ученые уже могут производить новые роговицы для слепых, а также выращивать крошечные волоски во внутреннем ухе, возможное лечение или даже излечение от некоторых видов глухоты.
Взрослые и эмбриональные стволовые клетки
Стволовые клетки присутствуют у взрослых людей, и многие люди задаются вопросом, почему ученые не могут просто использовать стволовые клетки взрослых для своих исследований. Причины этого кроются в различиях между взрослыми и эмбриональными стволовыми клетками. Взрослые стволовые клетки способны развиваться только в определенные типы клеток организма. Например, гемопоэтическая стволовая клетка способна образовывать только клетки крови. Ограниченное количество стволовых клеток существует во многих органах тела, включая мозг и сердце.
Небольшое количество доступных взрослых стволовых клеток и ограничения на то, какими клетками они могут в конечном итоге стать, — это лишь некоторые из причин, по которым ученые используют эмбриональные стволовые клетки для исследований. Стволовые клетки, найденные в человеческих эмбрионах, могут развиваться в клетки любого типа, и ученые называют эту уникальную способность плюрипотентностью . Эти плюрипотентные стволовые клетки делятся быстро и в больших количествах, что облегчает их изучение учеными.
Большинство эмбриональных стволовых клеток получают из эмбрионов, хранящихся в клиниках экстракорпорального оплодотворения . Эти эмбрионы будут пожертвованы пар , которые сохранили их, после получения информированного согласия. Хотя информации по этому вопросу мало, некоторые эмбрионы жертвуются женщинами, которые делают аборт после такого же процесса информированного согласия.
Противоречие
В то время как большинство людей понимают, что исследования стволовых клеток имеют определенную медицинскую ценность, многие возражают против использования эмбриональных стволовых клеток, потому что внутренняя масса клеток эмбриона удаляется, чтобы ученые могли выращивать и культивировать стволовые клетки. Это удаление разрушает эмбрион, что является частью исследования эмбриональных стволовых клеток, которое американцы, выступающие за жизнь, считают неприемлемым.
Важно отметить, что создание эмбриона путем искусственного оплодотворения с единственной целью исследования является полностью незаконным в соответствии с федеральным законом. Ученые не могут создать «эмбрионы морских свинок». На момент написания этой статьи федеральное правительство не финансирует создание новых линий стволовых клеток, но разрешает федеральное финансирование исследований линий стволовых клеток, созданных в частном порядке.
Как человеческий эмбрион связан со стволовыми клетками?
Ученые начали изучать метод генетического перепрограммирования взрослых стволовых клеток, чтобы они стали похожими на плюрипотентные эмбриональные стволовые клетки. Этот метод может в конечном итоге устранить потребность в эмбриональных стволовых клетках, но только в том случае, если индуцированные плюрипотентные стволовые клетки существенно не отличаются от эмбриональных клеток человека.
В настоящее время ученые изучают возможность использования индуцированных плюрипотентных стволовых клеток для моделирования воздействия болезней на организм человека и для проведения исследований новых лекарств и их воздействия на организм человека. С развитием таких методов, возможно, будущие исследователи стволовых клеток не столкнутся с противоречиями и горячими дебатами своих предшественников.